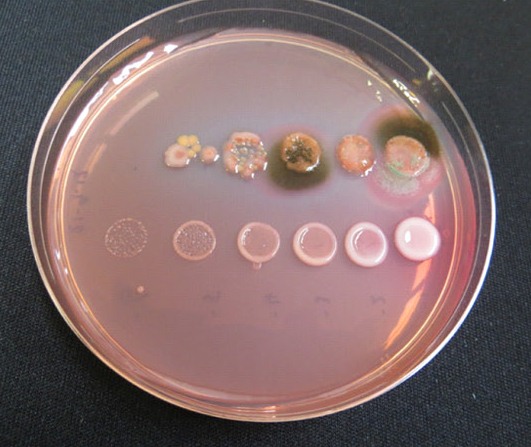

До прикладу, якщо Ви знаходитесь на відкритому просторі, на Вас тиснутиме стовп повітря із вмістом 6 т азоту. Повітря, яке знаходиться над одним гектаром поверхні поля, містить 80 тис. т азоту. Проте доступним для рослин він стає лише за симбіотичної азотфіксації, що здійснюється бульбочковими бактеріями. До речі, такий симбіотичний зв’язок бактерій із бобовими рослинами є унікальним на планеті Земля, і немає аналогів у рослинному світі.
 Примусове щеплення насіння бобових бактеріальними препаратами (інокулянтами) називається інокуляція. Після висіву інокульованого насіння бульбочкові бактерії (ризобії) проростають у вигляді тонких волосків та інфікують молоде коріння рослини. Після проникнення у кореневий волосок вони викликають інтенсивне ділення клітин кореня, внаслідок чого з’являється бульбочка. Самі бактерії розвиваються у них на коренях, беручи участь в асиміляції азоту.
Примусове щеплення насіння бобових бактеріальними препаратами (інокулянтами) називається інокуляція. Після висіву інокульованого насіння бульбочкові бактерії (ризобії) проростають у вигляді тонких волосків та інфікують молоде коріння рослини. Після проникнення у кореневий волосок вони викликають інтенсивне ділення клітин кореня, внаслідок чого з’являється бульбочка. Самі бактерії розвиваються у них на коренях, беручи участь в асиміляції азоту.
Перевірити ефективність азотфіксації дозволяє колір кореневих утворень, азот здатні фіксувати тільки бульбочки рожевого забарвлення, у яких локалізований червоний пігментний білок — леггемоглобін.
Однак господарю потрібно дуже ретельно вибирати інокулянти серед різноманіття препаратів, представлених на ринку. Чому? Позаяк неякісний продукт матиме ряд проблем, зокрема, нестерильний інокулянт викликатиме швидке зменшення концентрації бактерій та забруднення насіння шкідливими бактеріями. Дешеві препарати матимуть як низьку концентрацію бактерій, так і їх слабку життєздатність. Протерміновані продукти також будуть із низькою концентрацією бактерій та нульовою ефективністю.
Отже, як правильно вибрати ефективний якісний інокулянт? Передусім довіряти необхідно брендам, визнаним як у Європі, так і США, Канаді. Одним із таких виробників є Британська компанія Legume Technology Ltd, яка здійснює поставки своєї продукції у понад 30 провідних країн світу.
Фото. Доведена ефективність гамма-опромінення з метою виключення вмісту шкідливих бактерій. Представлені результати демонструють відрощування бактерій із препаратів конкурентів (верхній ряд) та інокулянтів на торфяній основі Legume Technology за різних концентрацій (нижній ряд) на живильному середовищі
В Україну продукти цього виробника на правах повного ексклюзиву постачає компанія Vitagro Partner, яка реалізує інокулянти під марками Premium Inoculant (сухий інокулянт на стерильній торфовій основі) та Premium Inoculant Forte (рідкий інокулянт). До речі, цього року Vitagro Partner отримала виключний ексклюзив ще на один інокулянт для сої на торф’яній основі Legume Fix.
Унікальність препарату Legume Fix полягає у тому, що торф´яна основа оброблена гамма-опроміненням, що забезпечує абсолютну стерильність упаковки. Використання «асептичного» наповнювача гарантує дотримання чистоти культури бактерій. Крім того, такий виробничий процес гарантує відмінний термін зберігання препарату в теплих умовах (у діапазоні температур, зазначених на упаковці). Ще одна особливість Legume Fix — це відселекційовані бактерії спеціально для ґрунтово-кліматичних умов України. А ще упаковка збільшеного вмісту — для зручності використання великими підприємствами.
Польові випробування цих інокулянтів показали значне збільшення урожаю сої в Канаді — понад 70%. Випробування на гороху у Великобританії продемонстрували збільшення врожаю на 20%, навіть на грунтах зі значною концентрацією природнього ризобію (результати 2016 року).

Проведені дослідження підтвердили і тривалу ефективну дію рідкого інокулянту Преміум Інокулянт Форте порівняно з конкурентними препаратами (мал. нижче).
Крім того, Преміум Інокулянт Форте має ряд інших беззаперечних переваг. Зокрема, у своєму складі містить два штами ефективних бактерій (Bradyrhizobium japonicum USDA442, Bradyrhizobium diazoefficiens SEIMA 5079 та SEIMA 5080) для кращої фіксації атмосферного азоту в різних ґрунтових умовах. Має екстендр, що дає можливість зберігати життєздатність бактерій на обробленому насінні протягом 14 днів. Містить ПАР з ефектом активного покриття для забезпечення більш рівномірного нанесення порівняно з сухими інокулянтами.
















